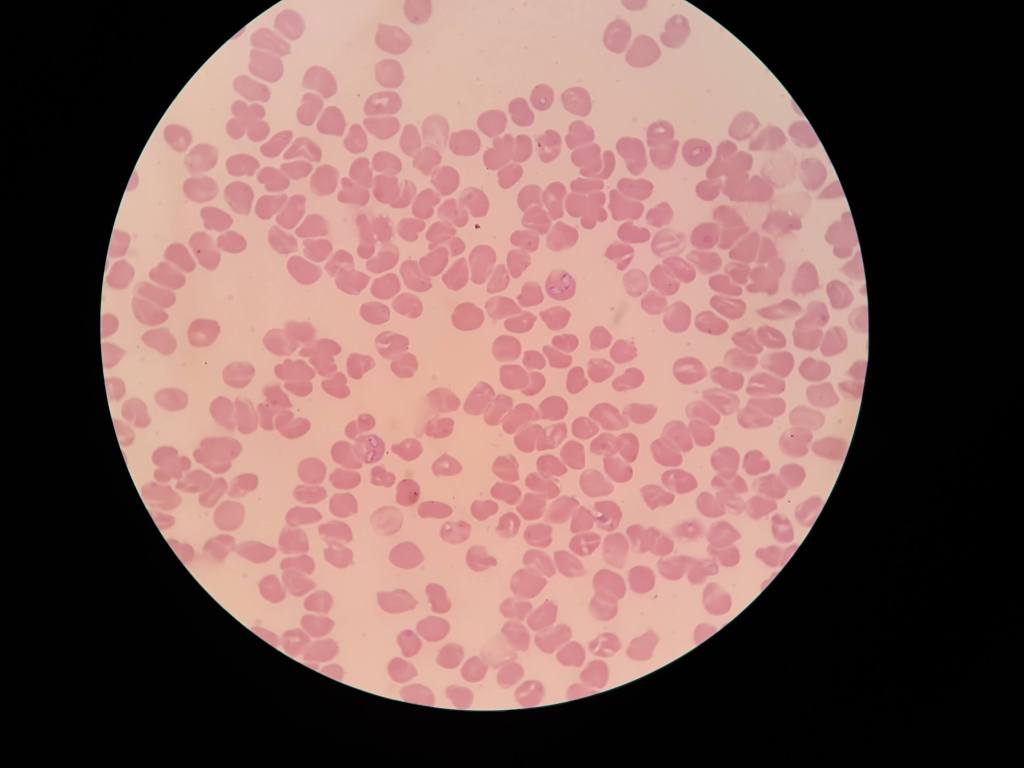

Babesiosis en perros: qué es y estrategias para evitarla
La babesiosis canina es una enfermedad transmitida por garrapatas de distribución mundial y con gran importancia en Latinoamérica. Tradicionalmente, se informaba como agentes etiológicos a dos especies distintas: Babesia canis y Babesia gibsoni. Estas se definían, al realizar el análisis citológico, según la morfología y tamaño como Babesia canis a las formas parasitarias grandes, con un tamaño de 5 x 2,5 µm, y como Babesia gibsoni a las pequeñas (2 x 1,5 µm). Con el advenimiento de las técnicas moleculares se identificaron tres subespecies de B.canis: B. canis vogeli, B. canis rossi y B. canis canis.Estos protozoarios parasitan los glóbulos rojos del hospedador causando diversas manifestaciones clínicas dependiendo del agente involucrado y las condiciones del animal. La distribución geográfica de las distintas especies de Babesia está directamente relacionada con la distribución de sus vectores: las garrapatas.

Distribución de la babesiosis canina y sus manifestaciones en la clínica
Para las subespecies de B.canis en caninos, el vector primario de B.vogeli es la garrapata marrón del perro (Rhipicephalus sanguineus), Dermacentor reticulatus es el vector de B.canis y Haemaphysalis elliptica de B.rossi. Dentro de estas, la subespecie más extendida en América Latina es B.vogeli debido a la prevalencia del vector R.sanguineus, que está presente en regiones tropicales y subtropicales, pero también en regiones más templadas como Argentina y Chile. Los demás vectores no han sido reportados en la región por lo que consecuentemente, la prevalencia de las demás subespecies productoras de babesiosis canina no se han informado.
La signología clínica dependerá de las condiciones del hospedero, como por ejemplo, su estado inmunitario y de la subespecie de Babesia involucrada. Por esto, el tratamiento preventivo para el control de su vector debe tener en cuenta condiciones especiales como animales gerontes, hembras
gestantes, lactantes. Para el caso de B. canis vogeli, la virulencia se describe como moderada a severa y dentro de sus principales manifestaciones clínicas se encuentran fiebre, anorexia, letargia y deshidratación. Como consecuencia de la ubicación intracelular del parásito en los eritrocitos, se producirá destrucción de los mismos provocando anemia, ictericia, bilirrubinemia y bilirrubinuria. También puede presentarse trombocitopenia y neutropenia.

El ciclo de vida de Babesia spp. y cómo prevenirla
El ciclo sexual de Babesia spp. se da en el hospedador definitivo (R.sanguineus) y la transmisión al perro se produce cuando la garrapata inocula formas infectantes, regurgitadas desde sus glándulas salivales, al torrente sanguíneo del paciente canino (hospedador intermediario). Estos hemoparásitos se replican de forma asexual en el interior de glóbulos rojos, produciendo estructuras denominadas merozoítos, causando la ruptura del glóbulo rojo y liberando merozoítos que invaden nuevos hematíes. Estas estructuras, al ser ingeridas por una garrapata que se esté alimentando del hospedador, se alojan en el ovario, penetran en los huevos y se transmiten a la nueva generación de garrapatas (pasaje transovárico). En estas garrapatas infectadas, cuando se produce la muda de larva a ninfa, los parásitos ingresan a las glándulas salivales permitiendo que el ciclo de vida de Babesia se concluya, al existir formas infectantes parasitarias disponibles en la saliva del vector. Cabe mencionar que la transmisión de la garrapata al perro puede ocurrir hasta después de las 48 hrs de fijación de la garrapata al hospedero.
Las características y condiciones del parásito establecen como única forma de prevención de la babesiosis canina, el control de las garrapatas en el animal. Esto hace referencia a evitar la adhesión de R.sanguineus en el animal, como así también la necesidad de cortar con el ciclo vital del ectoparásito. El período de incubación de Babesia spp. es de 10 a 28 días, por lo que la manifestación clínica se produce después de que el vector se ha alimentado e incluso separado del canino. R.sanguineus posee un ciclo de vida de tres hospederos, donde en cada etapa activa de su ciclo (larva, ninfa y adulto) se alimenta y parasita al canino, para luego caer al ambiente y continuar con su ciclo. Los períodos que ocurren en el ambiente, como la ovoposición y las mudas (larva-ninfa y ninfa-adulto) son largos y varían según condiciones ambientales. Un ciclo de vida completo, en condiciones favorables (temperaturas por encima de 18°C) puede darse en 63 días. No obstante, se ha reportado que garrapatas adultas han podido permanecer en el ambiente sin alimentarse durante 18 meses. Para evitar los períodos de falta de protección del paciente canino, se debe administrar un programa de desparasitación externa preventiva que actúe sobre adultos y estadios inmaduros, que posea efecto ambiental y con el máximo tiempo de eficacia posible (máximo número de semanas de protección). Mediante esta estrategia de prevención no será necesaria la aplicación de tratamientos curativos, sino que se reduce el riesgo de babesiosis y de otras enfermedades transmitidas por vectores que afectan directamente la salud de nuestros pacientes.
Bibliografía:
- Taylor, M.A., Coop, R.L. & Wall, R.L. (2016). Veterinary Parasitology. (4th ed.). Wiley-Blackwell.
- Panti-May, J.A., Rodríguez-Vivas, R.I. (2020). Canine babesiosis: A literature review of prevalence, distribution, and diagnosis in Latin America and the Caribbean. Veterinary Parasitology: Regional Studies and Reports. Volume 21, 100417, ISSN 2405-9390, https://doi.org/10.1016/j.vprsr.2020.100417.
- Birkenheuer, A.J., Buch J., Beall, M.J., Braff, J., Chandrashekar R. Global distribution of canine Babesia species identified by a commercial diagnostic laboratory. Veterinary Parasitology: Regional Studies and Reports. Volume 22, 2020, 100471, ISSN 2405-9390, https://doi.org/10.1016/j.vprsr.2020.100471.
Sigue leyendo sobre Una sola salud
- Fiebre aftosa: consecuencias en la salud pública y animalDescubre qué es la fiebre aftosa en bovinos, los aspectos epidemiológicos de esta enfermedad y las implicaciones socioeconómicas de sus brotes.
- Análisis APPCC: Identificación de riesgos y puntos críticos en la producciónDescubre cómo implementar el sistema de puntos críticos de control APPCC para garantizar la seguridad de los alimentos destinados a consumo humano.
- Cambio climático y su impacto en la proliferación de ectoparásitosDescubre por qué, teniendo en cuenta el cambio climático, los ectoparásitos actúan como vectores de enfermedades. ¡Conoce las medidas de control!
- Rickettsiosis: una zoonosis grave y potencialmente mortalDescubre qué es la rickettsia, cuáles son sus síntomas en adultos, cuál es el tratamiento adecuado para curar la rickettsiosis y cómo se previene